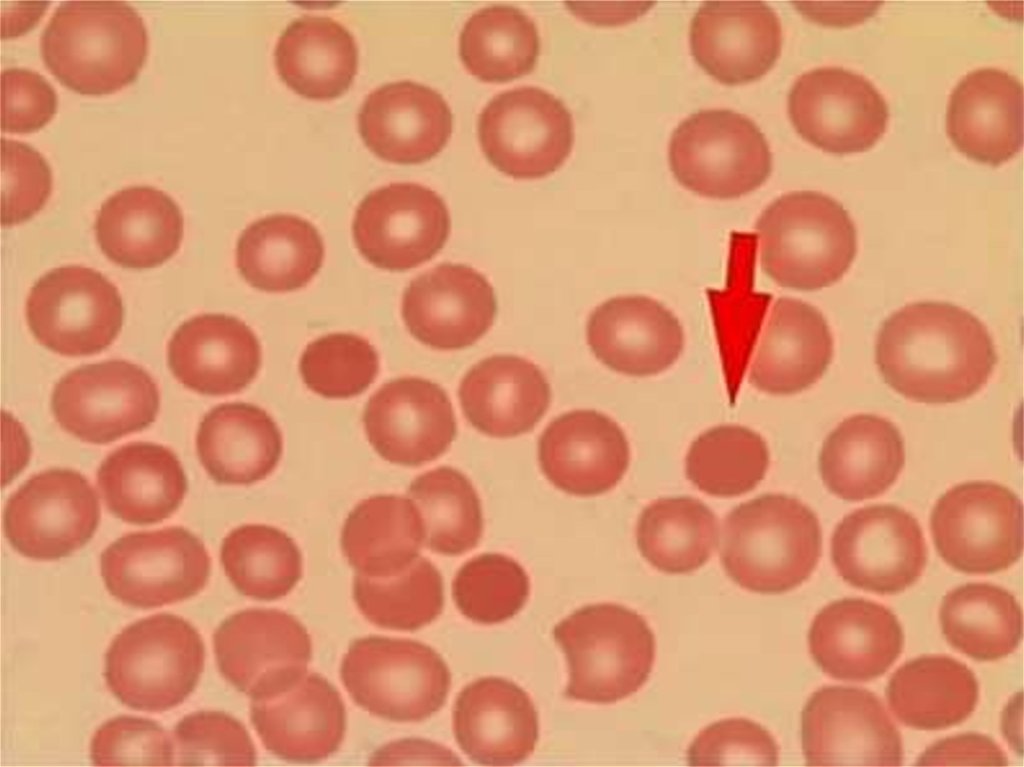

Похожие презентации:
Хирургическая анатомия селезенки. Спленэктомия. Показания, противопоказания, принципы и способы выполнения
1. Хирургическая анатомия селезенки. Спленэктомия. Показания, противопоказания, принципы и способы выполнения.
Лектор: Ячная Анастасия Олеговна4 леч 2 группа
6.10.2018
2.
3.
1549 г.- перваяспленэктомия.
Андриано
Заккиавелли
4.
5. 1866-95% летальный 1916 исход
1866-95% летальныйисход
1916
6.
7. Lien(splen)-в левом подреберье на уровне IX-XI ребер по средней подмышечной линии.
8.
9. Синтопия селезенки
10. Доли селезенки (васкулярные зоны): 1. Верхняя полярная 2. Верхняя срединная 3. Нижняя срединная 4. Нижняя полярная
11. Сегменты: -2непарных (концевых) -6 парных
12. Связочный аппарат
13.
14. 1. Короткие желудочные артерии 2. Левая желудочно-сальниковая
21
1. Короткие
желудочные
артерии
2. Левая
желудочносальниковая
15. По калибру селезеночная вена превышает артерию в 1.5-2 раза
По калибруселезеночн
ая вена
превышает
артерию в
1.5-2 раза
16.
17.
18.
19.
20.
21.
22.
23.
24.
25.
26.
27.
28.
29.
30.
31.
32.
33.
34.
35.
36.
37.
38.
39.
40.
41.
Осложнения:- Раневая инфекция
- Ателектаз легкого
- Выпот в левой плевральной
полости
- Постспленэктомический сепсис
- Тромбоцитоз

Медицина
Медицина








